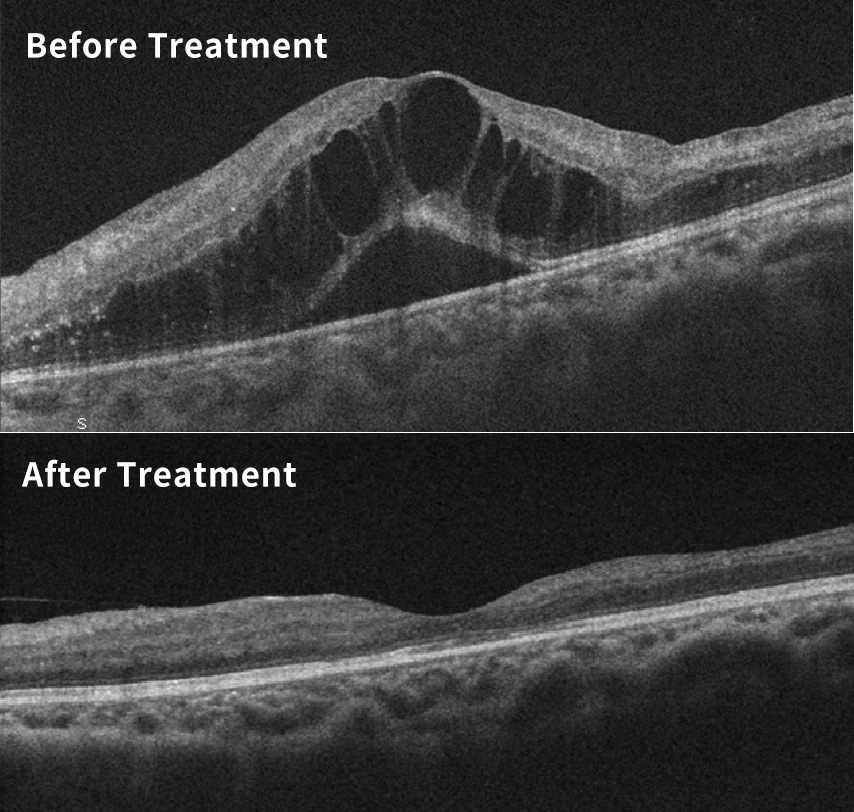

Diabetic macular edema
2025.09.04
Type 1 diabetes is a condition in which a body produces not enough insulin. Type 2 diabetes arises for insulin-resistant factors. Both cause high blood sugar and will lead to diabetic retinopathy. Almost type 1 diabetes patients will have diabetic retinopathy 15-20 years later, and 20%-30% of them will be blind; type 2 diabetes patients will have diabetic retinopathy about 20 years later. A quarter of the patients with diabetic retinopathy will have diabetic macular edema 15 years later.
The five questions below are frequently asked by the patients in ophthalmology.
The macula is at the center of the retina, in charge of the most important vision in the front. Macular edema is caused by the retinal capillary damage or abnormal angiogenesis, which results in blood vessel exudates and tissue edema.

“Does macular edema occur because my retinopathy is more serious?”
There’s no definitely positive relationship between macular edema and retinopathy. Diabetic retinopathy can be divided into four stages: mild non-proliferative, moderate non-proliferative, severe non-proliferative and proliferative. However, macular edema could occur in every stage. Preliminary non-proliferative retinopathy doesn’t necessarily cause visual decline, but once macular edema occurs, vision will obviously be affected.
Diabetic retinopathy, like diabetes, cannot be fully cured, but appropriate treatments can restore vision and alleviate the illness. In general, it’s fine for non-proliferative retinopathy to have regular follow-up at clinic; proliferative retinopathy needs laser treatment or vitrectomy. If macular edema occurs, often vision can be dramatically improved after receiving anti-angiogenic drugs injections into the eyeball.
Microangiopathy causes partial retinal ischemia, and the ischemia part will call for help and hope newly generated blood vessels to offer oxygen, and these abnormal blood vessels are the source of many complications, so the less the newly generated blood vessels, the better. The purpose of laser treatment is to let the oxygen-lacking cells not to call for help and alleviate the deterioration of the disease, so it cannot directly help improve vision.
Cells have metabolic memories, and retinopathy sometimes reflects the previous bad control record, but from now on, controlling blood sugar, blood pressure, renal functions, blood lipids, obesity, etc. could possibly stabilize the disease.
A diabetic needs to remember to have their retina checked regularly by an ophthalmologist!
TEL 02-2700-8069
Add Our Official LINE

2F, No. 263, Sec. 1, Dunhua S. Road,Da'an District, Taipei City 106, Taiwan
Our clinic operates by appointment only.